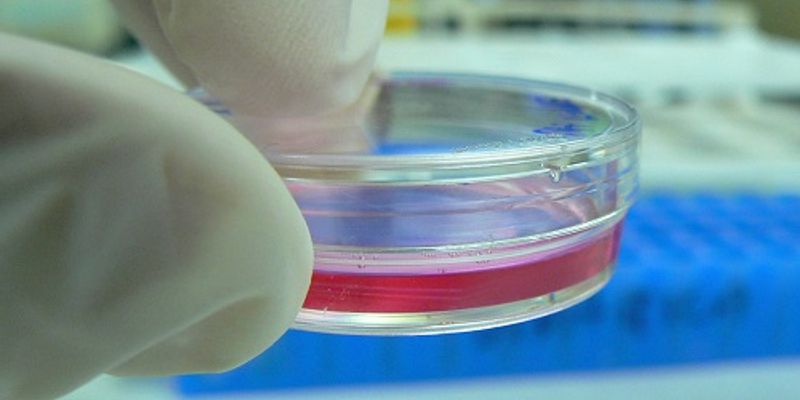

Cell Culture
Cell Culture: the process by which cells are grown under controlled conditions, generally outside of their natural environment. Cell culture conditions can vary for each cell type, but artificial environments consist of a suitable vessel with substrate or medium that supplies the essential nutrients (amino acids, carbohydrates, vitamins, minerals), growth factors, hormones, and gases (CO2, O2), and regulates the physio-chemical environment.
What's Popular in Cell Culture
-
DEC 09, 2025CancerWe generally consider cancer a disease of aging, as the rates of almost all types of cancer increase with age. Imm ...Written By: Katie KokolusNOV 20, 2025ImmunologyResearchers recently developed a bone marrow model to study how the body generates cells. Interestingly, this model is t ...Written By: Brian G. MorrealeOCT 15, 2025Cell & Molecular Biology3D cell cultures are no longer a futuristic idea. They’re already reshaping how we study diseases like cancer, off ...OCT 15, 2025Drug Discovery & DevelopmentThe host cell system is a critical determinant of recombinant protein quality and yield, with direct influence on protei ...SEP 02, 2025eBooksResearchers are under pressure to scale complex cell culture models-like iPSCs and 3D organoids-for high-throughput drug ...Sponsored By: Molecular Devices
DEC 09, 2025
Cancer
We generally consider cancer a disease of aging, as the rates of almost all types of cancer increase with age. Imm
...
Written By:
Katie Kokolus
NOV 20, 2025
Immunology
Researchers recently developed a bone marrow model to study how the body generates cells. Interestingly, this model is t
...
Written By:
Brian G. Morreale
OCT 15, 2025
Cell & Molecular Biology
3D cell cultures are no longer a futuristic idea. They’re already reshaping how we study diseases like cancer, off
...
OCT 15, 2025
Drug Discovery & Development
The host cell system is a critical determinant of recombinant protein quality and yield, with direct influence on protei
...
SEP 02, 2025
eBooks
Researchers are under pressure to scale complex cell culture models-like iPSCs and 3D organoids-for high-throughput drug
...
Sponsored By:
Molecular Devices
SEP 01, 2025
Immunology
Automated liquid handling solutions help to accelerate the development of biotherapeutics Conventional treatment options
...
Sponsored By:
INTEGRA Biosciences
AUG 05, 2025
eBooks
As 3D cell culture becomes a cornerstone of modern R&D, achieving consistency and reproducibility in liquid handling
...
JUL 01, 2025
Microbiology
Bacteria can be ruthless. A new study has shown that when their survival is threatened because of food scarcity, they wi
...
Written By:
Carmen Leitch
MAY 14, 2025
Microbiology
Bacterial cells have colonized every part of our world. But even though some can evade disinfectants to live in NASA cle
...
Written By:
Carmen Leitch
-
The emergence of advanced computational design tools, combined with breakthrough technologies in molecular biology and sequencing, has revolutionized protein engineering. Current cell therap...
OCT 29, 2025 | 8:00 AM
In today’s rapidly evolving landscape of next-generation sequencing (NGS), researchers face mounting pressure to deliver high-quality data from increasingly diverse and challenging sam...
OCT 14, 2025 | 10:00 AM
Stem cells and organoids are revolutionising medical advancements. The journey from stem cell research to translational medicine is extensive, and maintaining quality throughout development...
Speaker:
Pasquale Cutolo, PhD
, Sara Pérez Muñoz
, Paula Rendeiro
, Bettina Moser
, Alessandro Markus
Sponsored By: Thermo Fisher Scientific
OCT 08, 2025 | 9:00 AM
Cell counting is a fundamental step in many workflows, including cell culture, cell analysis, transfection, single cell sequencing, and cell therapy. Automated cell counters have improved th...
SEP 09, 2025 | 9:00 AM
C.E. CREDITS
Corneal transplantation using donor tissue is currently the primary treatment for corneal endothelial insufficiency. Despite the potential for vision restoration through corneal transplantat...
The emergence of advanced computational design tools, combined with breakthrough technologies in molecular biology and sequencing, has revolutionized protein engineering. Current cell therap...
OCT 29, 2025 | 8:00 AM
In today’s rapidly evolving landscape of next-generation sequencing (NGS), researchers face mounting pressure to deliver high-quality data from increasingly diverse and challenging sam...
OCT 14, 2025 | 10:00 AM
Stem cells and organoids are revolutionising medical advancements. The journey from stem cell research to translational medicine is extensive, and maintaining quality throughout development...
Speaker:
Pasquale Cutolo, PhD
, Sara Pérez Muñoz
, Paula Rendeiro
, Bettina Moser
, Alessandro Markus
Sponsored By: Thermo Fisher Scientific
OCT 08, 2025 | 9:00 AM
Cell counting is a fundamental step in many workflows, including cell culture, cell analysis, transfection, single cell sequencing, and cell therapy. Automated cell counters have improved th...
SEP 09, 2025 | 9:00 AM
C.E. CREDITS
Corneal transplantation using donor tissue is currently the primary treatment for corneal endothelial insufficiency. Despite the potential for vision restoration through corneal transplantat...
AUG 26, 2025 | 8:00 AM
Cell culture has been practiced since the mid-1800s. Many of the cell culture products that we use today were developed over 50 years ago. While these foundational products have led to many...
JUL 15, 2025 | 9:00 PM
The adult mammalian heart bears limited regenerative capacity, resulting in the irreversible loss of cardiomyocytes post-cardiac injury, and often culminating in end-stage heart failure. Car...
APR 30, 2025 | 8:00 AM
The purification of proteins and antibodies is a critical process in biotechnology and pharmaceutical industries. Traditional methods often involve single-use materials, leading to high cost...
MAR 20, 2025 | 8:00 AM
Efficient viral vector production is essential for the cost-effective manufacture of cell and gene therapies. Many of the current production workflows are reliant on basal media in batch-mod...
-
Experience the forefront of pharmaceutical innovation as Labroots and the Drug Discovery and Development planning committee host the 9th Annual Event in the Drug Discovery & Development...Labroots is excited to host the 8 th Annual Event in the Bioprocessing Virtual Event Series on April 1st, 2026! Bioprocessing, at its core, is the art and science of transforming raw materia...Labroots and the Cell Biology Planning Committee are pleased to announce the 10 th Annual Event in the Cell Biology Virtual Event Series 2026 on September 16th, 2026 . This event provides an...Experience the forefront of pharmaceutical innovation as Labroots and the Drug Discovery and Development planning committee host the 10 th Annual Drug Discovery & Development Virtual Eve...Labroots is excited to host the 9 th Annual Event in the Bioprocessing Virtual Event Series on March 31st, 2026! Bioprocessing, at its core, is the art and science of transforming raw materi...
Experience the forefront of pharmaceutical innovation as Labroots and the Drug Discovery and Development planning committee host the 9th Annual Event in the Drug Discovery & Development...
Labroots is excited to host the 8 th Annual Event in the Bioprocessing Virtual Event Series on April 1st, 2026! Bioprocessing, at its core, is the art and science of transforming raw materia...
Labroots and the Cell Biology Planning Committee are pleased to announce the 10 th Annual Event in the Cell Biology Virtual Event Series 2026 on September 16th, 2026 . This event provides an...
Experience the forefront of pharmaceutical innovation as Labroots and the Drug Discovery and Development planning committee host the 10 th Annual Drug Discovery & Development Virtual Eve...
Labroots is excited to host the 9 th Annual Event in the Bioprocessing Virtual Event Series on March 31st, 2026! Bioprocessing, at its core, is the art and science of transforming raw materi...
Labroots and the Cell Biology Planning Committee are pleased to announce the 11 th Annual Event in the Cell Biology Virtual Event Series 2027 on September 15th, 2027 . This event provides an...
NOV 04, 2025
| 8:00 AM PST
Discover a new and simple way to advance your protein research with automated solutions from Bio-Techne! Our virtual event series will showcase how you can leverage these revolutionary techn...
SEP 17, 2025
| 6:00 AM PDT
C.E. CREDITS
Labroots and the Cell Biology Planning Committee are pleased to announce the 9 th Annual Event in the Cell Biology Virtual Event Series 2025 on September 17th, 2025 . This event provides an...
SEP 10, 2025
| 6:30 AM PDT
Join us for Innovations in Cancer Research Solutions , a 10-part virtual event showcasing the latest technologies advancing cancer research. From optimizing cell culture systems to studying...